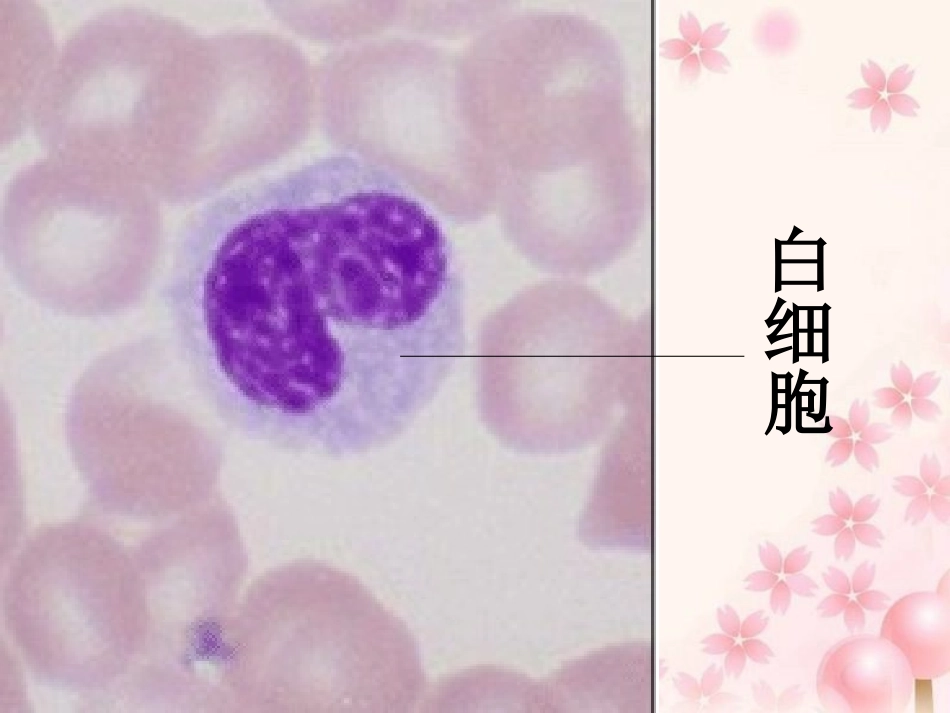

白细胞洋葱表皮细胞正在分裂的植物细胞骨骼肌细胞人的口腔上皮细胞在显微镜下我们能看到形形色色的细胞,反映了细胞的多样性
造成不同种类细胞形态结构不同的原因:细胞具有不同的形态结构是因为生物体内的细胞所处的位置不同,功能不同,是细胞分化的结果
洋葱表皮细胞洋葱表皮细胞呈长方体形状,排列紧密,有利于起到保护作用
例如,红细胞呈两面凹的圆饼状,这有利于与氧气充分接触,起到运输氧气的作用;这些细胞却又有着相似的基本结构:细胞膜细胞质细胞核——这反映了细胞的统一性观察图中大肠杆菌的细胞,它与上述细胞有什么不同
(绝大多数)细胞原核细胞幻灯片14真核细胞原核生物真核生物蓝藻、细菌、放线菌、支原体、衣原体,立克次氏体植物、动物、真菌(酵母菌、霉菌、大型真菌)科学家根据细胞内有无以核膜为界限的细胞核,将细胞分为两大类:大肠杆菌霍乱弧菌淋病球菌小技巧:凡是“菌”前面有“杆”、“球”、“螺旋”、“弧”都是细菌
水华:水体富营养化一般来说,我们用肉眼是分辨不清蓝藻细胞的,但是当它们以细胞群体的形式存在时,我们可能见过——淡水水域污染、富营养化,会长出讨厌的水华,其中就有多种蓝藻
2007年太湖蓝藻爆发市民抢购纯净水工人处理蓝藻颤藻、蓝球藻、念珠藻(发菜)等属于蓝藻发菜也属于蓝藻,在我国盛产于西北草地和荒漠,形如乱发,颜色乌黑,得名“发菜”
因发菜跟“发财”谐音,所以人们特别喜欢它,不惜以重金购买馈赠亲朋或制作佳肴
通过对发菜的营养成分分析,发菜的营养价值不是太高,有一定的药用价值
只是由于发菜与“发财”谐音,迎合了人们图吉利的心理,因而刺激了消费
再这样发菜真的要绝了再这样发菜真的要绝了过渡的采挖破坏了生态过渡的采挖破坏了生态(百万大军搂发菜阿拉善在哭泣)蓝藻细胞内含有藻蓝素和叶绿素,是能进行光合作用的自养生物,细菌中的绝大多数种类是营腐生或寄生生活的异养生物
在蓝藻和细菌的细胞中,都没有成